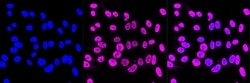
Invitrogen Phospho-STAT1 (Ser727) Recombinant Rabbit Monoclonal Antibody

missing translation for 'onlineSavingsMsg'
Learn More
Learn More
Invitrogen™ Phospho-STAT1 (Ser727) Recombinant Rabbit Monoclonal Antibody (23GB4190), Invitrogen™
Rabbit Recombinant Monoclonal Antibody
Brand: Invitrogen™ MA553709
This item is not returnable.
View return policy
Description
STAT1 (signal transducers and activators of transcription 1) is a member of the STAT family of transcription factors. STAT1 can be activated by interferon-alpha, interferon-gamma, EGF, PDGF and IL6. STAT1 is known to regulate several genes which are involved in cell growth, apoptosis, immune responses, and lipid metabolism. Further, STAT1 plays an important role in mediating cell viability in response to different cell stimuli and pathogen exposure. The STAT1 gene is located on chromosome 2. STAT1 is activated to regulate gene expression in response to extracellular signaling polypeptides including cytokines, interferons, and growth factors. After phosphorylation by JAK tyrosine kinases, STAT1 enters the nucleus to regulate transcription of many different genes. Among the seven STATs types, STAT1, STAT3, STAT5a, and STAT5b have a wide activation profile. STAT1 is activated by many different ligands including IFN family (IFN-Alpha, IFN-Beta, IFN-gamma and IL-10), gp130 family (IL-6, IL-11, LIF, CNTF, and G-CSF), and receptor tyrosine kinases (EGF, PDGF, and CSF-1). Two alternatively spliced transcript variants encoding distinct isoforms of STAT1 have been described.
Specifications
| Phospho-STAT1 (Ser727) | |
| Recombinant Monoclonal | |
| 0.6 mg/mL | |
| PBS with 50% glycerol and 0.02% sodium azide; pH 7.4 | |
| P42224, P42225 | |
| STAT1 | |
| A synthesized peptide derived from human Phospho-STAT1 (Ser727) (720-734AA). | |
| 20 μL | |
| Primary | |
| Human, Mouse, Rat | |
| Antibody | |
| IgG |
| Flow Cytometry, Western Blot, Immunocytochemistry | |
| 23GB4190 | |
| Unconjugated | |
| STAT1 | |
| 2010005J02Rik; AA408197; CANDF7; DD6G4-4; DKFZp686B04100; IMD31A; IMD31B; IMD31C; ISGF-3; LOW QUALITY PROTEIN: signal transducer and activator of transcription 1-alpha/beta; OTTHUMP00000165046; OTTHUMP00000205845; signal transducer and activator of transcription 1; signal transducer and activator of transcription 1, 91kD; signal transducer and activator of transcription 1, 91kDa; signal transducer and activator of transcription 1-alpha/beta; signal transducer and activator of transcription-1; STAT; STAT 1; STAT1; STAT-1; stat1 alpha; STAT91; transcription factor ISGF-3; transcription factor ISGF-3 components p91/p84 | |
| Rabbit | |
| Affinity chromatography | |
| RUO | |
| 20846, 25124, 6772 | |
| -20°C | |
| Liquid |
Product Content Correction
Your input is important to us. Please complete this form to provide feedback related to the content on this product.
Product Title
Spot an opportunity for improvement?Share a Content Correction